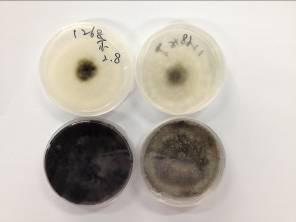

![]() |
地址:東莞市南城區元美路華凱廣場B座1208-1211 |
![]() |
咨詢熱線:18024333072 |
![]() |
微信公眾號 |
![]() |
木包裝,又稱木箱、木托盤、木框、木桶、木軸、木楔、墊木、枕木、襯木。但是,經人工合成或者經加熱、加壓等深度加工的包裝用木質材料(如膠合板、纖維板等)除外;還有薄板旋切芯、鋸屑、木絲、刨花等以及厚度等于或小于6mm的木質材料也除外。
?
博裕木材進口報關行告訴您,從2009年7月1日起,中國嚴格按照國際植物保護公約組織(International Plant Protection Convention)簡稱IPPC的要求進行辦理。
?
木包裝原來是長這樣的

?
高大挺拔,生活在美妙的大自然環境中。不過在感受陽光雨露微風的同時,也容易被病蟲害侵犯。
?
天牛科
一類較為重要的木材鉆蛀型害蟲,它的為害,能直接造成樹木的死亡。
?


?
小蠹科
一類主要為害原木的害蟲。其主要的危害性是在樹木的形成層或木質部內蛀坑道為害,可直接造成樹木枯死,嚴重時,可造成毀壞森林后果。
?

?
為害狀!

曲顎乳白蟻
中文別名:大家白蟻, 是東南亞地區危害活樹最危險的一種白蟻,其繁殖快、危害重、防治難,不僅危害木質結構的建筑物、貯藏品,而且還危害農林作物、活樹等,并能作遠距離的傳播擴散。
?

?
雙鉤異翅長蠹
?

?
為害狀!

?
樹蜂科
?

?
松材線蟲
松材線蟲病又稱松樹萎蔫病。是松樹的一種毀滅性流行病。該病危害的毀滅性在于:致病力強,寄主死亡速度快;傳播快,且常常猝不及防;一旦發生,治理難度大。
?

?
蘋果殼色單隔孢潰瘍病
我國明確規定禁止入境的檢疫性有害生物,可危害蘋果、梨、桃、葡萄、櫟樹、柏樹等多種植物,引起枝干的潰瘍和干枯癥狀,導致葉片黃化枯萎,還可引起蘋果等果實的腐爛。
?

為害狀(1)
?
為害狀(2)

?
這些有害生物在加工的過程中沒有辦法消除,可能就藏在我身上,跟著我瞞天過海跑到國外去了。為了避免小木在各國間貿易往來到處傳播有害生物,并將檢疫處理措施對國際貿易影響程度降到最低,ISPM15號公告應運而生。
?
此公告中規定“木包裝”要進行以下植物檢疫措施:
?
熱處理(HT)
木質包裝材料必須根據特定時間-溫度程序進行熱處理,這種程序實現木料的整體(包括木芯)達到在最低溫度56℃下至少持續30分鐘時間。目前有蒸汽熱處理設施、干熱風熱處理設施、導熱油熱處理設施等3種方式。


?
蒸汽熱處理設施

?


?
干熱風熱處理設施

?
導熱油熱處理設施



?
熱處理曲線圖

?
熏蒸處理(MB)
采用溴甲烷來熏蒸木質包裝材料必須按照程序進行,熏蒸最低溫度不低于10℃,時間不少于16小時。(新規定熏蒸時間不少于24小時。)
?
處理標識的樣式:




?


IPPC——《國際植物保護公約》的英文縮寫;
XX——國際標準化組織(ISO)規定的中國國家編碼;
000——出境貨物木質包裝標識加施企業的三位數登記號,按直屬檢驗檢疫局分別編號;
YY——除害處理方法,溴甲烷熏蒸-MB,熱處理-HT
?
當然啦,不是誰都可以給木包裝進行檢疫處理的。ISPM15號規定,出口國需向國家植物保護組織(National Plant Protection Organization , 簡稱NPPO)通報木質包裝檢疫處理企業和標識的使用情況。
?
在我國,由國家質檢總局負責對出境木質包裝檢疫除害處理企業進行考核,并對外公布名單。每件木包裝經過檢疫除害處理后,都會在它們身上打下一個烙印(IPPC)。
?


這就是木包裝
?
博裕進口木材報關行有專業的報關團隊幫您解決進口疑難,為您排憂!更多詳情請咨詢在線客服或撥打進口免費熱線:400-0724-200